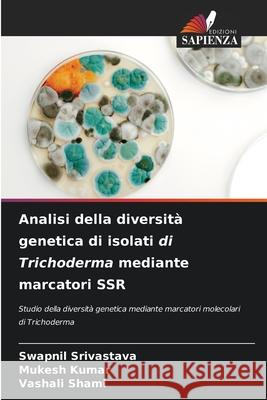
Analisi della diversit? genetica di isolati di Trichoderma mediante marcatori SSR Swapnil Srivastava Mukesh Kumar Vashali Shami 9786207592920
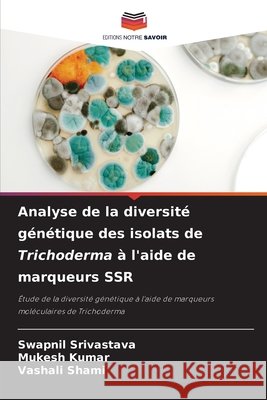
Analyse de la diversit? g?n?tique des isolats de Trichoderma ? l'aide de marqueurs SSR Swapnil Srivastava Mukesh Kumar Vashali Shami 9786207592913

topmenu
Wyniki wyszukiwania:
wyszukanych pozycji: 11
 |
Genetische diversiteitsanalyse van Trichoderma-isolaten
ISBN: 9786208357672 / Holenderski / Miękka / 2024 / 116 str. Termin realizacji zamówienia: ok. 10-14 dni roboczych. |
cena:
274,96 |
 |
Genetic diversity analysis of Trichoderma isolates
ISBN: 9783659302954 / Angielski Termin realizacji zamówienia: ok. 10-14 dni roboczych. |
cena:
274,96 |
 |
An?lise da diversidade gen?tica de isolados de Trichoderma usando marcadores SSR
ISBN: 9786207592883 / Portugalski Termin realizacji zamówienia: ok. 10-14 dni roboczych. |
cena:
274,96 |
|
Analisi della diversit? genetica di isolati di Trichoderma mediante marcatori SSR
ISBN: 9786207592920 / Włoski Termin realizacji zamówienia: ok. 10-14 dni roboczych. |
cena:
274,96 |
|
Analyse de la diversit? g?n?tique des isolats de Trichoderma ? l'aide de marqueurs SSR
ISBN: 9786207592913 / Francuski Termin realizacji zamówienia: ok. 10-14 dni roboczych. |
cena:
274,96 |
 |
Analyse der genetischen Vielfalt von Trichoderma-Isolaten mit SSR-Markern
ISBN: 9786207592890 / Niemiecki Termin realizacji zamówienia: ok. 10-14 dni roboczych. |
cena:
274,96 |
 |
Genetic Diversity Analysis of Trichoderma Isolates Using SSR Markers
ISBN: 9786207639489 / Angielski Termin realizacji zamówienia: ok. 10-14 dni roboczych. |
cena:
274,96 |
 |
Analyse der genetischen Vielfalt von Trichoderma-Isolaten
ISBN: 9786208357511 / Niemiecki / Miękka / 2024 / 116 str. Termin realizacji zamówienia: ok. 10-14 dni roboczych. Trichoderma ist eine Pilzgattung aus der Familie der Hypocreaceae, die in allen Arten von Böden vorkommt und der am häufigsten kultivierbare Pilz ist. Sie kommen weltweit vor und können leicht aus dem Boden, organischem Pflanzenmaterial, verrottendem Holz usw. isoliert werden. Er ist ein bekanntes aggressives Biokontrollmittel und hat ein hohes Reproduktions- und Kolonisierungspotenzial. In dieser Studie wurde die genetische Vielfalt von vierzehn Trichoderma-Isolaten (TBT- 01 bis TBT- 14) anhand von zehn SSR-Markern bewertet. Rhizosphärische Bodenproben von verschiedenen Standorten in...
Trichoderma ist eine Pilzgattung aus der Familie der Hypocreaceae, die in allen Arten von Böden vorkommt und der am häufigsten kultivierbare Pilz is...
|
cena:
274,96 |
 |
Análise da diversidade genética de isolados de Trichoderma
ISBN: 9786208357719 / Portugalski / Miękka / 2024 / 116 str. Termin realizacji zamówienia: ok. 10-14 dni roboczych. |
cena:
274,96 |
 |
Analisi della diversità genetica degli isolati di Trichoderma
ISBN: 9786208357603 / Włoski / Miękka / 2024 / 112 str. Termin realizacji zamówienia: ok. 10-14 dni roboczych. |
cena:
274,96 |
 |
Analyse de la diversité génétique des isolats de Trichoderma
ISBN: 9786208357597 / Francuski / Miękka / 2024 / 116 str. Termin realizacji zamówienia: ok. 10-14 dni roboczych. Trichoderma est un genre de champignons de la famille des Hypocreaceae que l'on trouve dans tous les types de sols et qui est le champignon cultivable le plus commun. Ils sont présents dans le monde entier et peuvent être facilement isolés du sol, de la matière organique des plantes, du bois en décomposition, etc. Il s'agit d'un agent de biocontrôle agressif bien connu qui possède un potentiel élevé de reproduction et de colonisation. Dans cette étude, la diversité génétique de quatorze isolats de Trichoderma (TBT- 01 à TBT- 14) a été évaluée à l'aide de dix marqueurs SSR....
Trichoderma est un genre de champignons de la famille des Hypocreaceae que l'on trouve dans tous les types de sols et qui est le champignon cultivable...
|
cena:
274,96 |










